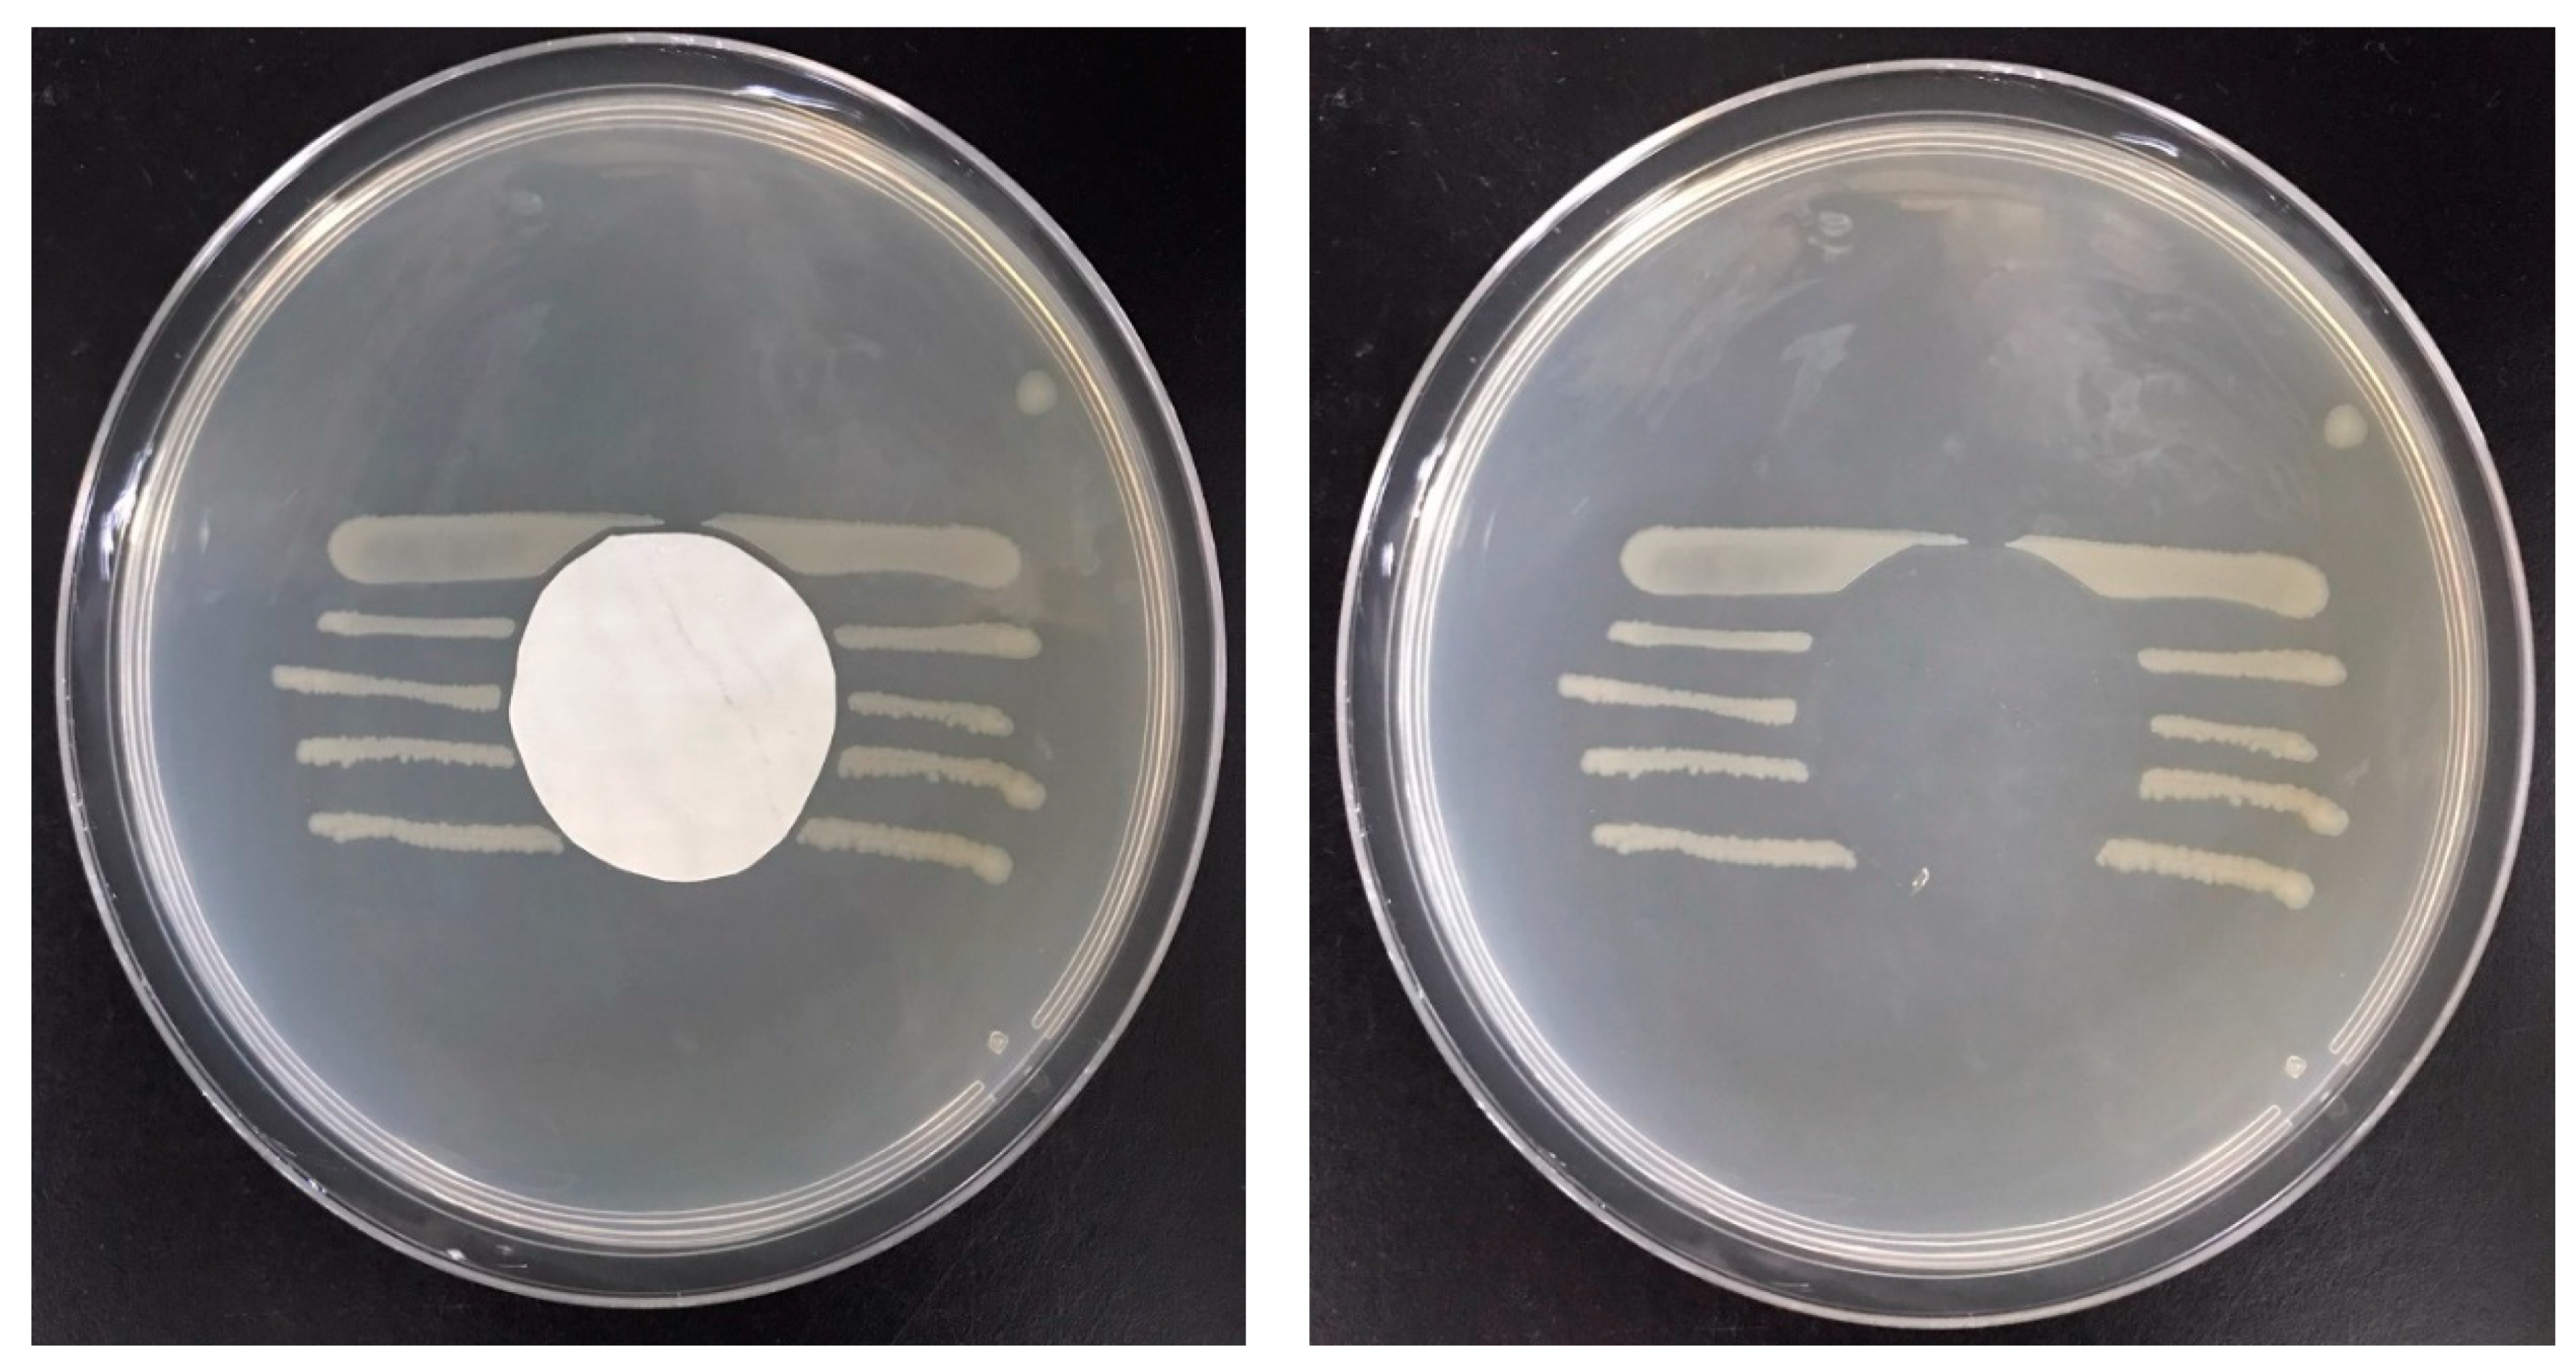
Membranes 12 00332 g010

Electrospinning of Quaternized Chitosan-Poly(vinyl alcohol) Composite Nanofiber Membrane: Processing Optimization and Antibacterial Efficacy
Abstract
:1. Introduction
2. Materials and Methods
2.1. Materials
2.2. Preparation and Physical Characteristics of Nanofiber Membranes
2.2.1. Preparation of PVA–Chitosan Nanofiber Membrane
2.2.2. Preparation of HTCC
2.2.3. Determination of Degree of Quaternization of HTCC
2.2.4. Preparation of PVA–HTCC Nanofiber Membrane
2.2.5. Measuring the Diameter of the Nanofibers
2.3. Water Solubility Test
2.4. Antibacterial Analysis
2.5. Assessment of Cytotoxicity of Nanofiber Membranes
3. Results and Discussion
3.1. FTIR Spectra of Nanofiber Membranes
3.2. Degree of Quaternization of HTCC
3.3. Optimization Process of PVA–Chitosan Nanofiber Membranes
3.4. Optimization Process of PVA–HTCC Nanofiber Membrane
3.5. Water Solubility of PVA–HTCC Nanofiber Membranes
3.6. Antibacterial Performances of Nanofiber Membranes
3.6.1. PVA–Chitosan Nanofiber Membrane
3.6.2. Antibacterial Efficacy of PVA–HTCC Nanofiber Membrane
3.6.3. Cytotoxicity of Nanofiber Membranes
4. Conclusions
Author Contributions
Funding
Data Availability Statement
Conflicts of Interest
References
- Agarwal, S.; Wendorff, J.H.; Greiner, A. Use of electrospinning technique for biomedical applications. Polymer 2008, 49, 5603–5621. [Google Scholar] [CrossRef] [Green Version]
- Lim, C.T. Nanofiber technology: Current status and emerging developments. Prog. Polym. Sci. 2017, 70, 1–17. [Google Scholar]
- Qiu, Q.; Chen, S.; Li, Y.; Yang, Y.; Zhang, H.; Quan, Z.; Qin, X.; Wang, R.; Yu, J. Functional nanofibers embedded into textiles for durable antibacterial properties. Chem. Eng. J. 2020, 384, 123241. [Google Scholar] [CrossRef]
- Schneiderman, S.; Zhang, L.; Fong, H.; Menkhaus, T.J. Surface-functionalized electrospun carbon nanofiber mats as an innovative type of protein adsorption/purification medium with high capacity and high throughput. J. Chromatogr. 2011, 1218, 8989–8995. [Google Scholar] [CrossRef]
- Yoo, H.S.; Kim, T.G.; Park, T.G. Surface-functionalized electrospun nanofibers for tissue engineering and drug delivery. Adv. Drug Del. Rev. 2009, 61, 1033–1042. [Google Scholar] [CrossRef]
- Pillay, V.; Dott, C.; Choonara, Y.E.; Tyagi, C.; Tomar, L.; Kumar, P.; du Toit, L.C.; Ndesendo, V.M. A review of the effect of processing variables on the fabrication of electrospun nanofibers for drug delivery applications. J. Nanomater. 2013, 2013, 789289. [Google Scholar] [CrossRef] [Green Version]
- Persano, L.; Andrea Camposeo, A.; Tekmen, C.; Pisignano, D. Industrial Upscaling of Electrospinning and Applications of Polymer Nanofibers: A Review. Macromol. Mater. Eng. 2013, 298, 504–520. [Google Scholar] [CrossRef]
- Çay, A.; Miraftab, M.; Kumbasar, E.P.A. Characterization and swelling performance of physically stabilized electrospun poly (vinyl alcohol)/chitosan nanofibres. Eur. Polym. J. 2014, 61, 253–262. [Google Scholar] [CrossRef]
- Ahmed, F.E.; Lalia, B.S.; Hashaikeh, R. A review on electrospinning for membrane fabrication: Challenges and applications. Desalination 2015, 356, 15–30. [Google Scholar] [CrossRef]
- Kulkarni Vishakha, S.; Butte Kishor, D.; Rathod Sudha, S. Natural polymers—A comprehensive review. Int. J. Res. Pharm. Biomed. Sci. 2012, 3, 1597–1613. [Google Scholar]
- Ashleigh, C.; Raehael, O.; Hongyan, M. Chitosan-based nanofi-bous membnmes for antibacterial filter applications. Carbohy-Drate Polym. 2013, 92, 254–259. [Google Scholar]
- Kong, M.; Chen, X.G.; Xing, K.; Park, H.J. Antimicrobial properties of chitosan and mode of action: A state of the art review. Int. J. Food Microbiol. 2010, 144, 51–63. [Google Scholar] [CrossRef] [PubMed]
- Verlee, A.; Mincke, S.; Stevens, C.V. Recent developments in antibacterial and antifungal chitosan and its derivatives. Carbohydr. Polym. 2017, 164, 268–283. [Google Scholar] [CrossRef]
- Bahrami, S.; Nouri, M. Chitosan-poly (vinyl alcohol) blend nanofibers: Morphology, biological and antimicrobial properties. e-Polymers 2009, 133, 1–12. [Google Scholar]
- Kohsari, I.; Shariatinia, Z.; Pourmortazavi, S.M. Antibacterial electrospun chitosan-polyethylene oxide nanocomposite mats containing ZIF-8 nanoparticles. Int. J. Biol. Macromol. 2016, 91, 778–788. [Google Scholar] [CrossRef]
- Wang, Z.; Yan, F.; Pei, H.; Li, J.; Cui, Z.; He, B. Antibacterial and environmentally friendly chitosan/polyvinyl alcohol blend membranes for air filtration. Carbohydr. Polym. 2018, 198, 241–248. [Google Scholar] [CrossRef] [PubMed]
- Hu, D.; Wang, H.; Wang, L. Physical properties and antibacterial activity of quaternized chitosan/carboxymethyl cellulose blend films. LWT Food Sci. Technol. 2016, 65, 398–405. [Google Scholar] [CrossRef]
- Kim, C.H.; Choi, K.S. Synthesis and antibacterial activity of quaternized chitosan derivatives having different methylene spacers. J. Ind. Eng. Chem. 2002, 8, 71–76. [Google Scholar]
- Gao, Y.; Cranston, R. Recent advances in antimicrobial treatments of textiles. Text. Res. J. 2008, 78, 60–72. [Google Scholar]
- Cheah, W.Y.; Show, P.-L.; Ng, I.-S.; Lin, G.-Y.; Chiu, C.-Y.; Chang, Y.-K. Antibacterial activity of quaternized chitosan modified nanofiber membrane. Int. J. Biol. Macromol. 2019, 126, 569–577. [Google Scholar] [CrossRef] [PubMed]
- Procházková, L.; Rodríguez-Muñoz, Y.; Procházka, J.; Wanner, J. Simple spectrophotometric method for determination of polyvinylalcohol in different types of wastewater. Int. J. Environ. Anal. Chem. 2014, 94, 399–410. [Google Scholar] [CrossRef]
- Yang, M.-C.; Lin, W.-C. Surface modification and blood compatibility of polyacrylonitrile membrane with immobilized chitosan–heparin conjugate. J. Polym. Res. 2002, 9, 201–206. [Google Scholar] [CrossRef]
- Alipour, S.M.; Nouri, M.; Mokhtari, J.; Bahrami, S.H. Electrospinning of poly (vinyl alcohol)–water-soluble quaternized chitosan derivative blend. Carbohydr. Res. 2009, 344, 2496–2501. [Google Scholar] [CrossRef] [PubMed]
- Mi, X.; Vijayaragavan, K.S.; Heldt, C.L. Virus adsorption of water-stable quaternized chitosan nanofibers. Carbohydr. Res. 2014, 387, 24–29. [Google Scholar] [CrossRef]
- Deng, H.; Lin, P.; Xin, S.; Huang, R.; Li, W.; Du, Y.; Zhou, X.; Yang, J. Quaternized chitosan-layered silicate intercalated composites based nanofibrous mats and their antibacterial activity. Carbohydr. Polym. 2012, 89, 307–313. [Google Scholar] [CrossRef]
- Esparza, Y.; Ullah, A.; Boluk, Y.; Wu, J. Preparation and characterization of thermally crosslinked poly (vinyl alcohol)/feather keratin nanofiber scaffolds. Mater. Des. 2017, 133, 1–9. [Google Scholar] [CrossRef]
- Gutiérrez, M.C.; García-Carvajal, Z.Y.; Jobbágy, M.; Rubio, F.; Yuste, L.; Rojo, F.; Ferrer, M.L.; del Monte, F. Poly (vinyl alcohol) scaffolds with tailored morphologies for drug delivery and controlled release. Adv. Funct. Mater. 2007, 17, 3505–3513. [Google Scholar] [CrossRef] [Green Version]
- Han, Y.; Cao, Y.; Bolisetty, S.; Tian, T.; Handschin, S.; Lu, C.; Mezzenga, R. Amyloid Fibril-Templated High-Performance Conductive Aerogels with Sensing Properties. Small 2020, 16, 2004932. [Google Scholar] [CrossRef]
- Wu, J.-Y.; Ooi, C.W.; Song, C.P.; Wang, C.-Y.; Liu, B.-L.; Lin, G.-Y.; Chiu, C.-Y.; Chang, Y.-K. Antibacterial efficacy of quaternized chitosan/poly (vinyl alcohol) nanofiber membrane crosslinked with blocked diisocyanate. Carbohydr. Polym. 2021, 262, 117910. [Google Scholar] [CrossRef]
- Mi, X.; Heldt, C.L. Adsorption of a non-enveloped mammalian virus to functionalized nanofibers. Colloids Surf. B Biointerfaces 2014, 121, 319–324. [Google Scholar] [CrossRef]
- Wang, C.; Fan, J.; Xu, R.; Zhang, L.; Zhong, S.; Wang, W.; Yu, D. Quaternary ammonium chitosan/polyvinyl alcohol composites prepared by electrospinning with high antibacterial properties and filtration efficiency. J. Mater. Sci. 2019, 54, 12522–12532. [Google Scholar] [CrossRef]
- Bai, B.; Mi, X.; Xiang, X.; Heiden, P.A.; Heldt, C.L. Non-enveloped virus reduction with quaternized chitosan nanofibers containing graphene. Carbohydr. Res. 2013, 380, 137–142. [Google Scholar] [CrossRef] [PubMed]
- Hu, D.; Wang, L. Fabrication of antibacterial blend film from poly (vinyl alcohol) and quaternized chitosan for packaging. Mater. Res. Bull. 2016, 78, 46–52. [Google Scholar] [CrossRef]
- Lim, S.H.; Hudson, S.M. Synthesis and antimicrobial activity of a water-soluble chitosan derivative with a fiber-reactive group. Carbohydr. Res. 2004, 339, 313–319. [Google Scholar] [CrossRef]
- Khalaji, S.; Nadereh Golshan Ebrahimi, N.G.; Hosseinkhani, H. Enhancement of biocompatibility of PVA/HTCC blend polymer with collagen for skin care application. Int. J. Polym. Mater. Polym. Biomater. 2021, 70, 459–468. [Google Scholar] [CrossRef]
- Yu, Q.; Song, Y.; Shi, X.; Xu, C.; Bin, Y. Preparation and properties of chitosan derivative/poly (vinyl alcohol) blend film crosslinked with glutaraldehyde. Carbohydr. Polym. 2011, 84, 465–470. [Google Scholar] [CrossRef]
- Wu, J.; Su, Z.-G.; Ma, G.-H. A thermo-and pH-sensitive hydrogel composed of quaternized chitosan/glycerophosphate. Int. J. Pharm. 2006, 315, 1–11. [Google Scholar] [CrossRef]
- Lallai, A.; Mura, G.; Palmas, S.; Polcaro, A.M.; Baraccani, L. Degradation of para-hydroxybenzoic acid by means of mixed microbial cultures. Environ. Sci. Pollut. Res. 2003, 10, 221–224. [Google Scholar] [CrossRef]
- Ali, S.W.; Rajendran, S.; Joshi, M. Synthesis and characterization of chitosan and silver loaded chitosan nanoparticles for bioactive polyester. Carbohydr. Polym. 2011, 83, 438–446. [Google Scholar] [CrossRef]
- Zhang, X.; Geng, X.; Jiang, H.; Li, J.; Huang, J. Synthesis and characteristics of chitin and chitosan with the (2-hydroxy-3-trimethylammonium) propyl functionality, and evaluation of their antioxidant activity in vitro. Carbohydr. Polym. 2012, 89, 486–491. [Google Scholar] [CrossRef]
- Haider, A.; Haider, S.; Kang, I.K. A comprehensive review summarizing the effect of electrospinning parameters and potential applications of nanofibers in biomedical and biotechnology. Arab. J. Chem. 2018, 11, 1165–1188. [Google Scholar]
- Jia, Y.T.; Gong, J.; Gu, X.H.; Kim, H.Y.; Dong, J.; Shen, X.Y. Fabrication and characterization of poly (vinyl alcohol)/chitosan blend nanofbers produced by electrospinning method. Carbohydr. Polym. 2007, 67, 403–409. [Google Scholar] [CrossRef]
- Paipitaka, K.; Pornprac, T.; Mongkontalangc, P.; Techitdheera, W.; Pecharapaa, W. Characterization of PVA-Chitosan Nanofibers Prepared by Electrospinning. Procedia Eng. 2011, 8, 101–105. [Google Scholar] [CrossRef] [Green Version]
- Abdelgawad, A.M.; Hudson, S.M.; Rojas, O.J. Antimicrobial wound dressing nanofiber mats from multicomponent (chitosan/silver-NPs/polyvinyl alcohol) systems. Carbohydr. Polym. 2014, 100, 166–178. [Google Scholar] [CrossRef]
- Liu, Y.; Wang, S.; Lan, W. Fabrication of antibacterial chitosan-PVA blended film using electrospray technique for food packaging applications. Int. J. Biol. Macromol. 2018, 107, 848–854. [Google Scholar] [CrossRef] [PubMed]

Publisher’s Note: MDPI stays neutral with regard to jurisdictional claims in published maps and institutional affiliations. |
© 2022 by the authors. Licensee MDPI, Basel, Switzerland. This article is an open access article distributed under the terms and conditions of the Creative Commons Attribution (CC BY) license (https://creativecommons.org/licenses/by/4.0/).
Share and Cite
Wu, J.-Y.; Wang, C.-Y.; Chen, K.-H.; Lai, Y.-R.; Chiu, C.-Y.; Lee, H.-C.; Chang, Y.-K. Electrospinning of Quaternized Chitosan-Poly(vinyl alcohol) Composite Nanofiber Membrane: Processing Optimization and Antibacterial Efficacy. Membranes 2022, 12, 332. https://doi.org/10.3390/membranes12030332
Wu J-Y, Wang C-Y, Chen K-H, Lai Y-R, Chiu C-Y, Lee H-C, Chang Y-K. Electrospinning of Quaternized Chitosan-Poly(vinyl alcohol) Composite Nanofiber Membrane: Processing Optimization and Antibacterial Efficacy. Membranes. 2022; 12(3):332. https://doi.org/10.3390/membranes12030332
Chicago/Turabian StyleWu, Jheng-Yu, Chi-Yun Wang, Kuei-Hsiang Chen, You-Ren Lai, Chen-Yaw Chiu, Hung-Che Lee, and Yu-Kaung Chang. 2022. "Electrospinning of Quaternized Chitosan-Poly(vinyl alcohol) Composite Nanofiber Membrane: Processing Optimization and Antibacterial Efficacy" Membranes 12, no. 3: 332. https://doi.org/10.3390/membranes12030332
APA StyleWu, J.-Y., Wang, C.-Y., Chen, K.-H., Lai, Y.-R., Chiu, C.-Y., Lee, H.-C., & Chang, Y.-K. (2022). Electrospinning of Quaternized Chitosan-Poly(vinyl alcohol) Composite Nanofiber Membrane: Processing Optimization and Antibacterial Efficacy. Membranes, 12(3), 332. https://doi.org/10.3390/membranes12030332

